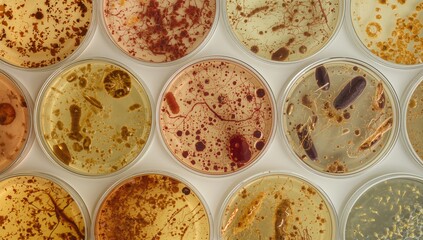
Set of cultural dishes showing microorganism growth on various agar media backgrounds, isolated samples, medical and pharmaceutical laboratory context

- Home >
- Stock Photos >
- Diverse Scientists Conducting Blood Research in Laboratory
Diverse Scientists Conducting Blood Research in Laboratory Image

Two female scientists, from diverse backgrounds, are depicted collaborating in a laboratory focused on blood research. They are examining medical samples while wearing lab coats, suggesting an atmosphere of cooperation and precision. This visual can be used for studies, articles, or promotional material related to scientific innovation, healthcare, medical research, and teamwork in laboratory settings.
2
downloads
downloads
Tags:
More
Credit Photo
If you would like to credit the Photo, here are some ways you can do so
Text Link
photo Link
<span class="text-link">
<span>
<a target="_blank" href=https://pikwizard.com/photo/diverse-scientists-conducting-blood-research-in-laboratory/ab83bf859b30d3b1815e177208c439be/>PikWizard</a>
</span>
</span>
<span class="image-link">
<span
style="margin: 0 0 20px 0; display: inline-block; vertical-align: middle; width: 100%;"
>
<a
target="_blank"
href="https://pikwizard.com/photo/diverse-scientists-conducting-blood-research-in-laboratory/ab83bf859b30d3b1815e177208c439be/"
style="text-decoration: none; font-size: 10px; margin: 0;"
>
<img src="https://pikwizard.com/pw/medium/ab83bf859b30d3b1815e177208c439be.jpg" style="margin: 0; width: 100%;" alt="" />
<p style="font-size: 12px; margin: 0;">PikWizard</p>
</a>
</span>
</span>
Free (free of charge)
Free for personal and commercial use.
Author: Creative Art
Similar Free Stock Images
Loading...